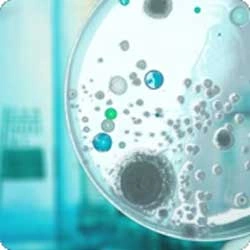

Learn the World
Lifelong learning is an extension of classrooms, books and theories. The DNA of Centurion is to offer ramps and ladders for multiple entry and exit by adopting and adapting the National Credit Framework.
Experience the World
The appropriate balance of knowledge and skills is key to making a real difference. Centurion learning labs are real-time, market-linked production hubs for immersive and competency-linked educational deliveries.
Change the World
The university and our students must transform societies and communities within which it exists - change begins with us and from within. The Centurion survives and thrives on disruptions and relevant innovations to co-create a holistic learning ecosystem.
Launch Your Career with India's Top NAAC A+ Ranked University
Glimpses of 
Industrial
Production Labs
Our Schools
and Technology

Applied sciences

pharmacy

& Bio-Engineering

& Allied health sciences

Law

Biotechnology

Nursing

Fisheries

media & communication

school of agriculture

management

forensic science

& Animal Sciences

Maritime Studies

Education and Training

Result of Almost Two Decades of Hardwork, Commitment & Empathy
0
Students
0
Courses
0
On-Campus Manufacturing Units
0
Industry-Sponsored Labs
0
Highest Package
Centurion University is India's No. 1 Skill University
 Centurion
University Ranked as India's No 1 Skill
University in India's Top
Universities Ranking 2024' by Outlook ICARE
Centurion
University Ranked as India's No 1 Skill
University in India's Top
Universities Ranking 2024' by Outlook ICARE Centurion
University cited prominently by name -which is
rare- in the UN General Assembly Report
by Secretary General on Right to education, for
the University's unique education
model.
Centurion
University cited prominently by name -which is
rare- in the UN General Assembly Report
by Secretary General on Right to education, for
the University's unique education
model. Notified
as
“CENTRE OF EXCELLENCE” of Ministry of skill
Development &
Entrepreneurship, Government of India.
Notified
as
“CENTRE OF EXCELLENCE” of Ministry of skill
Development &
Entrepreneurship, Government of India. Centurion
University is the FIRST University in India to
be accorded the status of Assessment and
Awarding Body Pan-India level by Government of
India.
Centurion
University is the FIRST University in India to
be accorded the status of Assessment and
Awarding Body Pan-India level by Government of
India. Acknowledgement
of
Centurion University by the hon'ble Union
minister of skill Development as a mode
to reckon with!
Acknowledgement
of
Centurion University by the hon'ble Union
minister of skill Development as a mode
to reckon with! Centurion
University showcased as a Case Study in the
UNESCO Publication for its unique and
scalable skill training education model.
Centurion
University showcased as a Case Study in the
UNESCO Publication for its unique and
scalable skill training education model. The
world bank
highlights the Uniqueness of Centurion
University in terms of its skill-integrated
higher education model.
The
world bank
highlights the Uniqueness of Centurion
University in terms of its skill-integrated
higher education model. Centurion
University is the ONLY University mentioned in
the “Best Practices of Our
States” SF Report of NITI Aayog.
Centurion
University is the ONLY University mentioned in
the “Best Practices of Our
States” SF Report of NITI Aayog. Centurion
University is Prominently acknowledged in the
report of MoSDE, Government of India, on
Marching Towards a Skilled India.
Centurion
University is Prominently acknowledged in the
report of MoSDE, Government of India, on
Marching Towards a Skilled India.
Centurion University Placements
Recruiters
Job Offers
Highest Placement Package
Success Stories
Specializations
Engineering
Specializations
Agriculture
Specializations
Applied Science
Allied Health Science Programs

Anesthesia Technology
Clinical Microbiology

Medical Laboratory Technology

Medical Radiation Technology

Nursing

Optometry

Physiotherapy
Management Programs

BBA

B.COM

BMS

MBA
Law Programs

BA. LLB

BBA. LLB

LLM
All Other Programs

Bachelor of Fisheries Science

Bachelor of Pharmacy

Bachelor of Veterinary Science

Diploma in Civil Engineering

Diploma in Automobile Enginering

Diploma in CSE

Diploma in Mining Engineering

Diploma in Pharmacy

Master of Pharmacy
Advanced Research Centers

Heavy Motor Vehicles Action
Learning Lab: Ashok
Leyland

Heavy Motor Vehicles Action
Learning Lab: Eicher

Light Weight Commercial Vehicle
Action Learning
Lab: Hyundai

Light Motor Vehicle With Gears
Action Learning
Lab: Yamaha

Advanced Material Testing
And Calibration

Surveying Laboratory: ONGC

Pavers Manufacturing Unit

Optometry And Ophthalmology:
HPCL

Aquaculture

Fish Processing Technology
Laboratory

Waste To Wealth

Apparel Manufacturing Unit

Waste To Wealth
Production Unit

Wood Engineering
Production Centre

Dassault Play Ground
(Go-To-Market Lab)

Agriculture
Production Lab
Apply for
Centurion University
Entrance
Exam(CUEE)
Academic year:
2025-2026
Quality
education, and fostering future
innovators and leaders since
1997.
Scholarship Available
Chandrika Scholarship
For
Girls
Scholarship For
JEE Rank
Holders
Scholarship For
Sports
Person
Scholarship For
Defence
Ward
Scholarship For
Merit
Scholarship
Apply Now
Need More Information?
If you're thinking about how to prepare for the next stage in your career, we can help. Request more information today.
Contact Us








.webp)


.webp)














































































